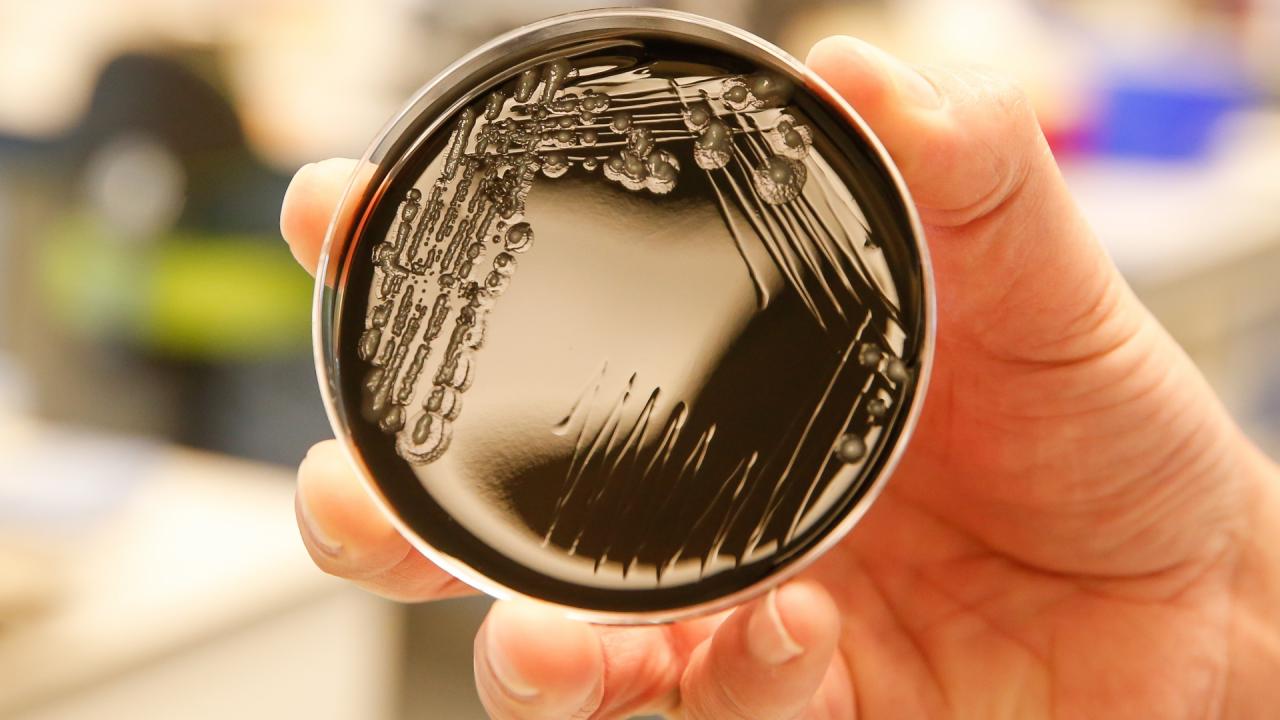

🚛Formation Intervention en Sécurité sur les Véhicules GNV / GNC
Interventions hors Haute Pression – Maintenance courante & environnement mécanique Contexte & enjeux des motorisations GNV/GNC Développement des flottes propres dans les collectivités Obligations réglementaires